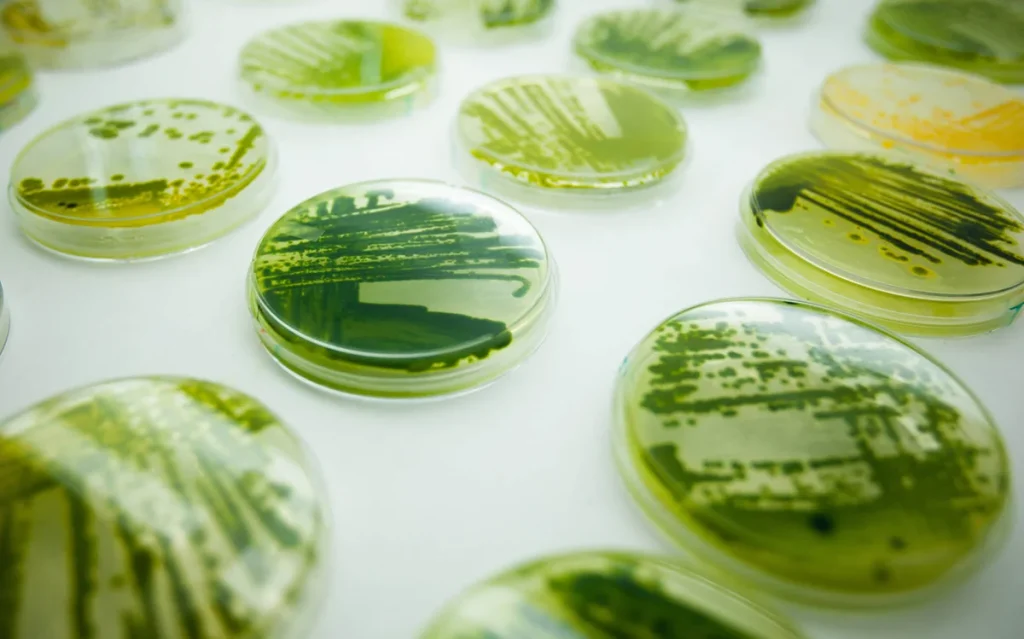
پلیت جلبک

تولید پروتئین پایدار و مغذی با کمترین آسیب به محیط زیست
دانشمندان دانشگاه کپنهاگ موفق به تولید رشتههای پروتئینی شبیه به فیبر عضله با استفاده از جلبک سبز آبی شدهاند .

این دستاورد، راه را برای تولید منابع پروتئینی پایدار و مغذی هموار میکند.
این پروتئین نهتنها با محیط زیست سازگار است، بلکه بافتی شبیه به گوشت دارد و به کمترین پردازش نیاز دارد.
همه ما میدانیم که باید مصرف گوشت را کاهش دهیم و به جای آن، بیشتر از غذاهای گیاهی استفاده کنیم.

اما وقتی از جلوی یخچال های پروتئین های حیوانی فروشگاهها عبور می کنیم ؛ انتخاب غذاهایی که با محیط زیست سازگار تر هستند سخت تر می شود و صدای عقل ما همیشه برنده نیست.
با اینکه طعم و مزه پروتئین های گیاهی بسیار بهتر شده است اما بافت شبیه به گوشت در آنها وجود ندارد.
حتی بعضی از پروتئین های گیاهی به علت مصرف سوخت زیاد برای فراوری نه تنها سازگار با محیط زیست نیستند بلکه مضر هم هستند.
انقلابی در صنعت غذایی با جلبک
تصور کنید غذایی وجود داشته باشد که با طبیعت سازگار باشد، غنی از پروتئین باشد و بافتی شبیه گوشت داشته باشد.

این غذای جدید، نویدبخش آیندهای پایدار و مغذی در صنعت غذایی است.
تحقیقات جدید دانشگاه کپنهاگ، گامی دیگر در جهت تحقق این چشم انداز است.
کلید معما، جلبکهای سبزآبی غیرسمی هستند.نه گونههای بدنامی که به خاطر سمی بودن و تلفات تابستانه در دریا شناخته میشوند.
دکتر جنسن میگوید : “سیانوباکتریها یا جلبکهای سبزآبی، موجودات زندهای هستند که میتوانیم آنها را به تولید پروتئینهایی وادار کنیم که به طور طبیعی قادر به ساخت آن نیستند.
نکته جالب اینجاست که پروتئینهای تولید شده توسط سیانوباکتریها، رشتههای فیبری هستند که تا حدودی شبیه به بافت گوشت هستند.
ممکن است بتوان از این فیبرها در پروتئینهای گیاهی استفاده کرد .پنیر یا غذاهای جدید دیگر که ما به دنبال بافت جدید در آن هستیم.
در این تحقیق جنسن و همکارانش در دانشگاه کپنهگ با همکاری سایر موسسات نشان دادند که سیانوباکتریها میتوانند به عنوان میزبان برای تولید پروتئینهای جدید مورد استفاده قرار گیرند.
رشتههای پروتئینی نانوفیبری ساخته شده در داخل سلول این جلبک با انتقال ژن به این سیانوباکتری ساخته شد.
کمترین فراوری بیشترین سازگاری با طبیعت
دانشمندان در سراسر جهان بر روی سیانوباکتریها و ریزجلبکها به عنوان غذاهای جایگزین تمرکز دارند.
به این دلیل که آنها توسط فتوسنتز رشد میکنند و البته خودشان شامل مقدار زیادی پروتئین و اسیدهای چرب غیراشباع مفید هستند .

دکتر جنسن می گوید : “من یک آدم متواضع روستایی هستم که کمتر هیجانات خود را نشان میدهم
ولی توانایی دستکاری یک ارگانیسم زنده برای تولید نوع جدیدی از پروتئین که آن ها را به صورت رشتههای سازماندهی میکند به ندرت دیده شده است و بسیار امیدوار کننده است”
جنسن میگوید : این جلبک به راحتی و به صورت پایدار میتواند رشد کند .
این جلبک برای زنده ماندن فقط نیاز به آب ، دی اکسید کربن موجود در اتمسفر و نور خورشید دارد .
این مزایا به سیانوباکتریها پتانسیل بیشتری میدهد که به عنوان یک عنصر پایدار مورد بررسی قرار گیرند .
محققان زیادی در سرتاسر جهان به دنبال موادی هستند تا بتوانند پروتئین غذاهای گیاهی را تقویت کنند ، مانند نخود فرنگی و سویا با این حال این مواد به فراوری زیادی نیاز دارند .

دانهها ابتدا باید آسیاب شوند و پروتئینها از آنها استخراج شوند تا به غلظت مناسب برسد .
اگر بتوانیم از کل سیانوباکتری در مواد غذایی استفاده کنیم، نه فقط نانوفیبر پروتئینی ساخته شده از آن، میزان فرآوری به طور قابل توجهی کاهش خواهد یافت.
جنسن میگوید: “در تحقیقات غذایی خود سعی میکنیم از فرآوری بیش از حد اجتناب کنیم، زیرا هم باعث کاهش ارزش غذایی مواد اولیه میشود و هم انرژی بالایی مصرف میکند.”
دام های گوشتی آینده
او تاکید میکند :”مقداری زمان میبرد تا تولید رشتههای پروتئینی از سیانوباکتریها شروع شود.
محققان ابتدا باید راهی برای بهینهسازی تولید پروتئین فیبری ساخته شده در سیانو باکتریها پیدا کنند .
جانسون بسیار خوشبین است.

او میگوید :”ما بایدجلبک ها را بیشتر اصلاح کنیم تا پروتئین فیبری بیشتری تولید کنند .
بدین ترتیب سیانو باکتریها را به خدمت خود میگیریم .
این کار شبیه به گاوهای شیری است که ما آنها را به خدمت گرفتهایم تا مقدار بسیار زیادی شیر برای ما تولید کنند.
با این تفاوت که در اینجا هیچ گونه ملاحظات اخلاقی در مورد رفاه حیوانات وجود ندارد.
ما نمیتوانیم همین فردا به هدف خود دست یابیم.
چند چالش متابولیکی وجود دارد که ما باید آنها را حل کنیم.
البته ما هم اکنون در حال بررسی این چالشها هستیم و من اطمینان دارم موفق میشویم.
اگر اینگونه بشود این بهترین روش برای تولید پروتئین است.”
سیانوباکتریهایی مثل اسپیرولینا در حال حاضر به صورت تجاری پرورش داده میشوند.

تولید این جلبک معمولا به صورت حوضچهای و در فضای روباز یا به صورت فتوبیورکتور در لولههای شیشهای انجام میشود.
جنسن می گوید : “دانمارک مکان مناسبی برای تاسیس کارخانههای میکرو جلبک برای تولید سیانو باکتریهای اصلاح شده است.
این کشور دارای شرکتهای زیست فناوری با مهارت لازم و بخش کشاورزی کارآمدی است.
کشور دانمارک همانطور که امروزه محصولات لبنی تولید میکند میتواند سیانوباکتریها و سایر ریز جلبکهای دیگر را نیز تولید کند.
این امکان وجود دارد که بخشی از سلول را به صورت روزانه به عنوان محصول تازه برداشت کرد یا به عبارتی دوشید.

با تغلیظ سلولهای سیانوباکتری مادهای شبیه به پستو به دست میآید که حاوی پروتئین فیبری است که با حداقل فرآوری میتواند مستقیماً وارد مواد غذایی شود .”
با کلیک بر روی آیکونهای زیر ما را در شبکههای اجتماعی دنبال کنید.
منبع خبر : University of Copenhagen

